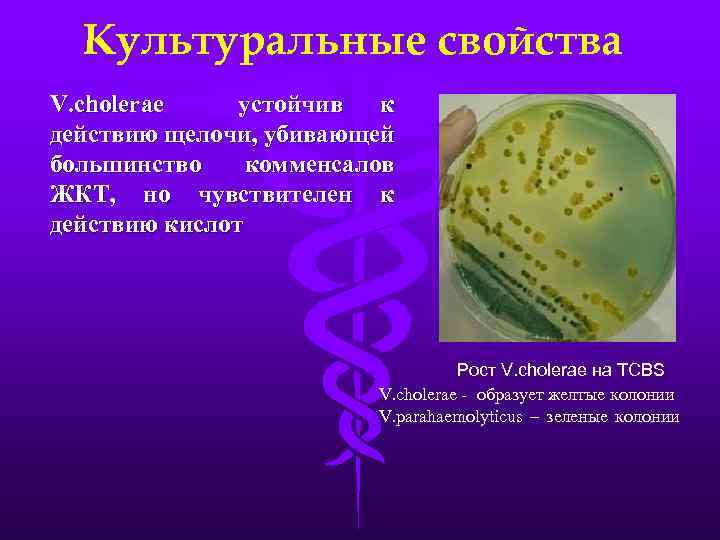
Культуральные свойства V. cholerae устойчив к действию щелочи, убивающей большинство комменсалов ЖКТ, но чувствителен

Вибрионы. Кампилобактерии.ppt
- Количество слайдов: 31

Вибрионы Кампилобактерии В. В. Леонов, 2013 Ханты-Мансийская государственная медицинская академия Кафедра биологии с курсом микробиологии

Вибрионы Отдел: Gracilicutes Семейство: Vibrionaceae Род: Vibrio Виды: V. cholerae V. parahaemoliticus V. vulnificus Электронограмма V. cholerae открыт 1883 -1884 гг Р. Кохом V. cholerae (чистая культура) окраска по Граму

Классификация вибрионов • Холерные • Холероподобные (НАГ-вибрионы) По Б. Хейбергу (способности ферментировать маннозу, сахарозу и арабинозу) выделяют 8 групп вибрионов I группа Хейберга Манноза+ Сахароза+ Арабиноза - V. сholerae

Холера (от греч. «chole» - жёлчь и «rheo» - теку) – бактериальная карантинная (конвенционная) ООИ с фекально-оральным механизмом передачи возбудителя. Характеризуется нарушением водно-солевого и белкового обмена, обезвоживанием, токсикозом и гастроэнтеритом

Классификация возбудителей холеры Вибрионы Диарейные заболевания Истинная холера О 139 О 1 V. cholerae Более 20 О-серогрупп Биовар Более 150 О-серогрупп Классический Эль-Тор Серовар Огава Инаба Хикошима О-Ag АВ АС АВС

Антигенная структура • О-антиген (полисахаридная часть ЛПС), термостабильный; по его специфичности выделяют 150 серогрупп, большинство непатогенны; возбудителями холеры являются представители серогрупп О 1 (V. cholerae биовар classic и V. cholerae eltor) и О 139 (V. cholerae Bengal) По сочетанию А, В, С компонентов О-антигена выделяют серотипы: Огава (А, В); Инаба (А, С); Хикошима (А, В, С) • Н-антиген – жгутиковый белок флагеллин, термолабильный, общий у всех возбудителей холеры • К-антиген только у V. cholerae Bengal Протективными антигенами считаются: О-Ag, Н-Ag, белки наружной мембраны, К-Ag для серогруппы О 139

Холерный вибрион Алгоритм серологической идентификации V. cholerae Vibrio O 1, RO + Cеровар – Cыворотки пассажи на ПВ + – Огава Инаба Огава ++ + Инаба + ++ + – Xикошима + + O 139 НАГ O 139
Культуральные свойства V. cholerae устойчив к действию щелочи, убивающей большинство комменсалов ЖКТ, но чувствителен к действию кислот Рост V. cholerae на TCBS V. cholerae - образует желтые колонии V. parahaemolyticus – зеленые колонии

Факторы патогенности Факторы адгезии и колонизации 1. Фимбриальные белки-адгезины (tcp-пили) Обеспечивают прикрепление к эпителиоцитам 2. Муциназа Расщепляет муцин и открывает доступ к рецептору холерогена – Gm 1 3. Подвижность и хемотаксис Мутанты: Mob- - авирулентны Che- - маловирулентны

Факторы патогенности Факторы вирулентности 1. Эндотоксин 2. Гидролазы (нейраминидаза, протеазы) 3. Энтеротоксин (холероген) Главный фактор патогенности V. cholerae!

Факторы патогенности Факторы защиты 1. Ферменты антиоксидантной защиты 2. Устойчивость при р. Н>7 3. Секреторные факторы 4. Некультивируемые формы

Эпидемиология V. сholerae – нормальный обитатель пресных и соленых водоемов, может находиться в воде или в организмах простейших и др. обитателей. Источник инфекции – больной или носитель (только для серовара El-Tor) Резервуар – водный Механизм передачи – фекально-оральный Эндемичные районы – Индия, Египет, Юго-Восточная Азия С 1817 г отмечены 7 пандемий: 6 из них вызывались V. сholerae classic, 7 -я - V. сholerae El-Tor В 1993 г холера в Бенгале была вызвана вариантом O 139 – отдельные исследователи считают это началом 8 -ой пандемии

ПАНДЕМИИ ХОЛЕРЫ В ЕВРОПЕ В XIX И XX ВЕКАХ

Еще немного истории … М. Петенкофер в 1893 г. после опыта самозаражения холерой

Патогенез Vibrio cholerae преодоление (если им это удалось) кислого содержимого желудка тонкий кишечник высокая подвижность преодоление пристеночной слизи муциназа разжижение пристеночной слизи нейраминидаза взаимодействие с микроворсинками эпителиоцитов колонизация эпителиальных клеток синтез эпителиоцитами в виде ответной реакции щелочного секрета, насыщенного желчью создание идеальной среды для размножения холерного вибриона секреция холерогена выход в просвет кишечника большого количества воды и растворенных в ней электролитов расстройство водно-солевого обмена различной степени тяжести

Клинические проявления Потеря воды и электролитов приводит к обезвоживанию организма: • Падает артериальное давление • Нарушается микроциркуляция • Развивается гипоксия тканей • Метаболический ацидоз • Гипокалиемия • Острая почечная недостаточность • Сердечная недостаточность Больной холерой (facies hippocratica – «гиппократово лицо» )

Лабораторная диагностика Материал: испражнения, ректальные мазки и др. Методы диагностики 1. Бактериологический – основной метод диагностики; 2. Серологические методы (опеделение антител против холерогена, агглютининов, вибриоцидных в сыворотке в реакциях агглютинации, бактериолиза, ИФА, РНГА ит. д. ); 3. Молекулярно-генетический метод (ПЦР для определения генов, кодирующих факторы патогенности); 4. Ускоренные методы диагностики (прямой иммунофлуоресцентный метод, метод иммобилизации вибрионов О 1 или О 139 -сывороткой при микроскопии в темном поле зрения, реакция микроагглютинации с холерной агглютинирующей О-сывороткой).

Терапия Симптоматическая – восстановление водноэлектролитного баланса: использование сухих регидратационных смесей или внутривенные вливания в тяжелых случаях. Состав смесей: Na. Cl, KCl, Na. HCO 3, глюкоза (для использования симпорта – канала совместного входа в клетку глюкозы и натрия, т. к. основной канал блокирован холерогеном) Патогенетическая – антибиотикотерапия (тетрациклины)

Профилактика Специфическая Вакцинация по эпидемическим показаниям: • вакцина холерная бивалентная химическая таблетированная – содержит холероген-анатоксин и О -Ag сероваров Инаба и Огава • вакцина холерная (холероген-анатоксин + О-Ag) жидкая Неспецифическая повышенные санитарно-гигиенические требования; употребление кислых продуктов (лимоны, уксус и т. д. )

Кампилобактерии Отдел: Gracilicutes Семейство: Campylobacteriaceae Роды: Campylobacter Helicobacter Виды: C. jejuni C. coli H. pylori Электронограмма H. рylori Хеликобактерии открыты 1983 г Б. Маршалом и Р. Уореном H. рylori (чистая культура) окраска по Граму

Факторы патогенности Campylobacter spp. 1. Штопорообразное движение 2. Белки-адгезины 3. Энтеротоксины Эпидемиология Резистентность в окружающей среде невысокая. В молоке сохраняются до 1 -5 недель Источник – животные, больные люди Путь – пищевой, водный и бытовой

Клинические проявления кампилобактериозов 1. Диареи (энтероколиты), в качестве осложнений могут развиваться аппендицит и перитонит 2. Сепсис 3. Внекишечные инфекции (менингиты, энцефалиты, эндокардиты) 4. Гнойно-воспалительные заболевания новорожденных 5. Заболевания ротовой полости

HELICOBACTER PYLORI – возбудитель язвенной болезни желудка и двенадцатиперстной кишки у человека Барри Маршал В 1985 г. австралийский врач Б. Маршал в опыте самозаражения показал способность H. pylori индуцировать развитие язвенного гастрита. Двумя годами позже новозеландские врачи A. J. Morris и G. I. Nicholson в аналогичном опыте подтвердили это наблюдение

Факторы патогенности H. pylori Факторы адгезии и колонизации 1. Пилиподобные структуры Связываются с мембранными гликолипидами и протеогликанами 2. ЛПС наружной мембраны Усиливает эффект адгезии 3. Штопорообразное движение Проникновение в вязкий слой слизи

Факторы патогенности H. pylori Факторы адгезии и колонизации 4. Уреаза Активность фермента очень высока Локализован на поверхности клетки NH 2 CONH 2 Уреаза CO 2 + NH 3 NH 4+ Нейтрализация НСl

Факторы патогенности H. pylori Факторы вирулентности 1. Вакуолизирующие токсины Vac. A и Cag. A (от англ. cytotoxin-assciated antigen) Повреждает эпителиоциты in vitro. 2. Фосфолипаза? 3. Прочие факторы антипролиферативной активности

Факторы патогенности H. pylori Факторы защиты 2. Секреторные факторы (АЛФА и др. ) 3. Сидерофоры

Патогенез Система гастриксинсоматотропин (дестабилизация) Т-лимфоциты Цитокины Гиперсекреция соляной кислоты Макрофаги Ферменты Цитотоксины, NH 4+, фосфолипаза Эпителиоцит H. pylori Деполимеризация слизи

Лабораторная диагностика Методы диагностики 1. Бактериологический (чистую культуру выделяют из эндоскопического биоптата) 2. Бактериоскопический (мазки-отпечатки биоптатов слизистой оболочки) 3. Серологический (определение титра антител к возбудителю) 4. ПЦР 5. Энзиматический (определение уреазной активности в биопсийном материале или содержимом желудка) 6. Респираторный тест

Лабораторная диагностика Методы диагностики 13 СО 2 (мк. М) 6. Респираторный тест Позитивный тест Н 2 N 13 CONH 2 (мочевина) Негативный тест Н 2 N 13 CONH 2 + Н 2 О Часы Уреаза NH 3 + 13 CO 2 Кровь 13 СО 2 в выдыхаемом воздухе

Терапия 1. Патогенетическая (антисекреторная терапия) 2. Этиотропная (антибиотики – метронидазол, амоксициллин и др. )
Вибрионы. Кампилобактерии.ppt